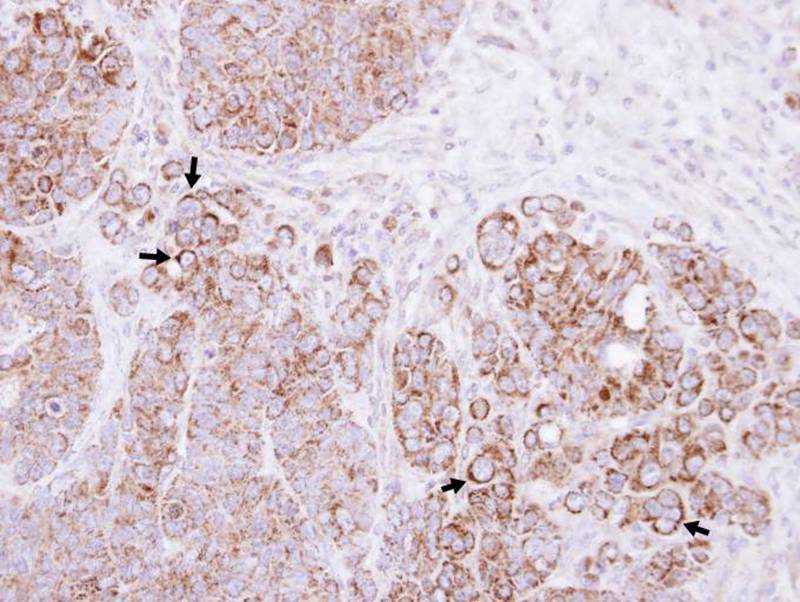
产品细节图片2

相关产品推荐更多 >
万千商家帮你免费找货
0 人在求购买到急需产品
- 详细信息
- 文献和实验
- 技术资料
- 免疫原:
Recombinant protein fragment contain a sequence corresponding to a region within amino acids 292 and 533 of Human CTNNAL1
- 形态:
liquid
- 保存条件:
Store at -20˚C
- 克隆性:
Polyclonal
- 适应物种:
Human
- 保质期:
12 months
- 抗原来源:
Rabbit
- 供应商:
南京赛戈巍生物科技有限公司
- 宿主:
Rabbit
- 应用范围:
WB IHC
- 抗体英文名:
Alpha-catulin antibody
- 规格:
50ul/100ul
应用详情:Predicted MW: 82kd
Western blotting: 1:500-1:3000
Immunohistochemistry: 1:100-1:250
图片:

Sample (30 ug of whole cell lysate)
A: Hela
B: Hep G2
7.5% SDS PAGE
Primary antibody diluted at 1: 1000
,
Immunohistochemical analysis of paraffin-embedded SW480 xenograft, using Alpha-catulin antibody at 1: 100 dilution.
风险提示:丁香通仅作为第三方平台,为商家信息发布提供平台空间。用户咨询产品时请注意保护个人信息及财产安全,合理判断,谨慎选购商品,商家和用户对交易行为负责。对于医疗器械类产品,请先查证核实企业经营资质和医疗器械产品注册证情况。
 文献和实验
文献和实验【求助】矛盾的实验结果:IKb alpha和NFKB同时升高
吴佰霖 我的基因过表达,结合文献,推理应该是IKb alpha下降,而NFKB升高 (IKb可磷酸化NFKB,使后者降低) 但现在我的结果是两者同时升高,请问可能的原因有哪些呢? 谢谢 woxingwosu 可否检测一下NFKB的磷酸化情况? erik NFKB是检测核内的吗?检测p65还是p50/ 吴佰霖 检测总蛋白
ALPHA FACTOR ARREST AND RELEASE
Alpha Factor Arrest and Release Alpha factor stock is 10-3 M in 0.1N HCl (i.e. resuspend 5 mg alpha factor in 2.97 ml 0.1N HCl). To arrest BAR1 strains, the pheromone should be diluted to a final concentration
LABELING ALPHA-ACTININ WITH IATR
. 8.IATR (tetramethylrhodamine iodoacetamide; Moledular Probes). Procedure (perform under reduced light) 1.Get 2 mg gizzard alpha-actinin,stored in 2 mM PIPES,0.02% azide,pH 7.0 in liquid nitrogen.Thaw quickly in warm water and chill in ice. 2.Resuspend
 技术资料
技术资料暂无技术资料 索取技术资料






![DYRK2 Rabbit Polyclonal Antibody[55079]](https://img1.dxycdn.com/p/s14/2025/0922/498/0460884283108299691.jpg!wh200)
![LRRC7 Polyclonal Antibody[27905]](https://img1.dxycdn.com/p/s14/2025/0923/305/2150219664296040791.jpg!wh200)
![PAK7 Conjugated Antibody[C35292]](https://img1.dxycdn.com/p/s14/2025/0923/278/4431488150116040791.jpg!wh200)

